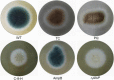

cis-9-Hexadecenal, a Natural Compound Targeting Cell Wall Organization, Critical Growth Factor, and Virulence of Aspergillus fumigatus
- PMID: 32391495
- PMCID: PMC7203908
- DOI: 10.1021/acsomega.0c00615
cis-9-Hexadecenal, a Natural Compound Targeting Cell Wall Organization, Critical Growth Factor, and Virulence of Aspergillus fumigatus
Abstract
Aspergillus fumigatus causes several nosocomial pulmonary infections and accounts for high morbidity and mortality rate globally. Among various virulence factors, 1,8-dihydroxynaphthalene-melanin plays an important role in the survival during unfavorable conditions both in vivo and in vitro, masks various molecular patterns associated with A. fumigatus, and protects it from the host immune system. In the present study, we aim to understand the potential of cis-9-hexadecenal as an antimelanogenic compound and its role in modulating other associated virulence factors in A. fumigatus. cis-9-Hexadecenal is a bioactive compound that belongs to C16 mono-unsaturated fatty-aldehyde groups. Minimum effective concentration of cis-9-hexadecenal affecting A. fumigatus melanin biosynthesis was determined using broth microdilution method. The spectrophotometric analysis revealed reduced melanin content (91%) and hydrophobicity (59%) at 0.293 mM of cis-9-hexadecenal. Cell surface organizational changes using electron microscopy showed altered demelanized smooth A. fumigatus conidial surface without any protrusions after cis-9-hexadecenal treatment. The transcript analysis of polyketide synthase (PKS) pksP/alb1 gene was quantified through qRT-PCR which revealed an upregulated expression. Total proteome profiling conducted through LC-MS-MS showed upregulated PKS enzyme but other downstream proteins involved in the 1,8-dihydroxynaphthalene-melanin biosynthesis pathway were absent. The homology modeling of PKS using Expasy's web server predicted that PKS is stable at varied conditions and is hydrophilic in nature. The Ramachandran plot by PROCHECK confirmed the 3-D structure of PKS to be reliable. Docking analysis using AutoDock-4.2.6 predicted the binding of cis-9-hexadecenal and PKS at Thr-264 and Ser-171 residue via hydrogen bonding at a low binding energy of -4.95 kcal/mol.
Copyright © 2020 American Chemical Society.
Conflict of interest statement
The authors declare no competing financial interest.
Figures

References
-
- Scorzoni L.; de Paula e Silva A. C. A.; Marcos C. M.; Assato P. A.; de Melo W. C. M. A.; de Oliveira H. C.; Costa-Orlandi C. B.; Mendes-Giannini M. J. S.; Fusco-Almeida A. M. Antifungal therapy: new advances in the understanding and treatment of mycosis. Front. Microbiol. 2017, 8, 36.10.3389/fmicb.2017.00036. - DOI - PMC - PubMed
-
- Boominathan M.; Ramamurthy V. Antimicrobial activity of Heliotropium indicum and Coldenia procumbens. J. Ecobiol. 2009, 24, 11–15.
LinkOut - more resources
Full Text Sources
Miscellaneous